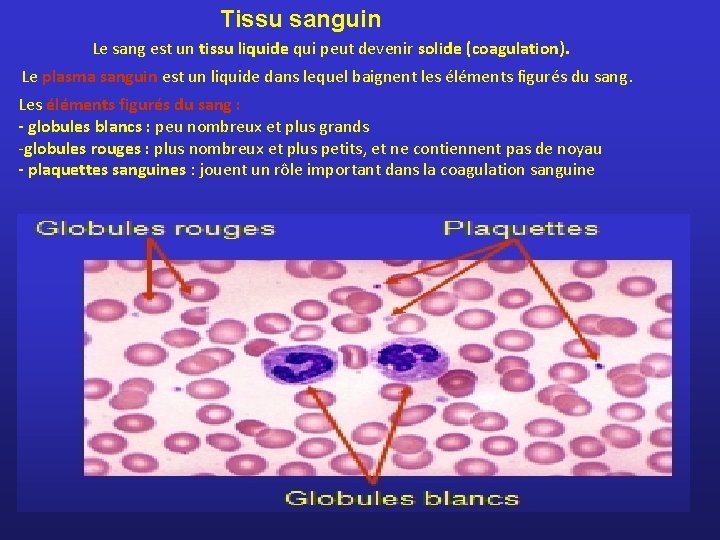

Rsum des tissus animaux Les pithliums Cellules soudes

- Slides: 20
Résumé des tissus animaux
Les épithéliums Cellules soudées Membrane basale • = tissus de revêtement: les cellules épithéliales forment des membranes qui tapissent les surfaces internes et externes du corps et des organes. • Formés de cellules serrées • Pas de vaisseaux sanguins : les cellules sont nourries par le liquide interstitiel qui diffuse à partir des tissus sous-jacents • Toutes les cellules reposent sur une membrane basale La membrane basale est sécrétée par les cellules épithéliales. Elle est surtout formée de glycoprotéines et de collagène. Elle sert à "ancrer" l'épithélium au tissu sous-jacent.
Types d’épithélium Épithélium pavimenteux (ou squameux) simple (une seule couche de cellules) Épithélium cubique simple Épithélium prismatique (ou cylindrique) simple Les épithéliums sont classés selon - la forme des cellules. - et le nombre de couches de cellules. Épithélium pavimenteux stratifié(plusieurs couches de cellules) Épithélium cubique stratifié Épithélium prismatique (cylindrique) stratifié Membrane basale
Dans certains cas, les cellules sont ciliées ou flagellées : Cellules responsables du déplacement du mucus dans les voies respiratoires. Cet épithélium recouvre les voies Les spermatozoïdes dans la lumière des tubes séminifères respiratoires. Certaines cellules de cet épithélium cylindrique simple sécrètent un liquide visqueux, le mucus. Ce mucus piège la plupart des poussières et bactéries qui risqueraient d'atteindre les fragiles alvéoles pulmonaires. Le mouvement des cils des cellules remonte constamment le mucus vers la gorge où il est avalé (ou craché par terre pour les plus malpropres!). La fumée de cigarette paralyse progressivement les cils de ces cellules. Les fumeurs doivent donc tousser pour réussir à évacuer le mucus de leurs voies respiratoires. À la longue, la fumée de cigarette irrite les voies respiratoires qui réagissent à cette irritation en sécrétant de plus en plus de mucus de plus en plus difficile à évacuer.
Épithéliums glandulaires Une glande EXOCRINE sécrète des substances hors du corps Une glande ENDOCRINE sécrète des substances dans le sang Ce sont des cellules épithéliales cubiques simples, des glandes thyroïdes qui fabriquent et sécrètent dans le sang l'hormone thyroxine : ce sont des glandes ENDOCRINES. . Ce sont également des cellules épithéliales qui forment les glandes sébacées, qui sécrètent le sébum (le sébum est un corps gras qui contribue à imperméabiliser la peau) : ce sont des glandes EXOCRINES. Les glandes MIXTES sont à la fois glandes ENDOCRINES et glandes EXOCRINES Comme les testicules qui - produisent des spermatozoïdes(glandes EXOCRINES) - et secrètent des testostérones (glandes ENDOCRINES).
FONCTIONNEMENT DES GLANDES Pour les Glandes ENDOCRINES Grâce aux TESTOSTERONES secrétées par les TESTICULES Pour les Glandes EXOCRINES Grâce aux ŒSTROGÈNES et PROGESTÉRONES secrétées par les OVAIRES Apparition des acnés Apparition de Pomme d’Adam Développement des seins Développement de carrure Elargissement du bassin Apparition des poils au pubis, aux aisselles, puis à la moustache Apparition des règles Ejaculation nocturne Accélération de la croissance des jambes (plus de 10 cm par an) De 12 à 18 ans Désir sexuel Accélération de la croissance des jambes (un peu faible) De 11 à 17 ans
Qu’est-ce que c’est ? La flèche jaune correspond à des cellules épithéliales pavimenteuses qui s'emplissent de kératine. Ces cellules sont mortes et elles se détachent continuellement en surface. L’épiderme humain vu en coupe (Épithélium pavimenteux stratifié ) La flèche rouge correspond à des cellules épithéliales qui se divisent activement pour remplacer les cellules supérieures au fur et à mesure qu'elles meurent et se détachent.
Tissus conjonctifs Les tissus conjonctifs sont formés de trois composantes: 1. Des cellules séparées les unes des autres 2. Des fibres protéiques : -fibres élastiques - fibres collagènes - fibres réticulaires 3. Une substance fondamentale (liquide ou solide)
Conjonctif lâche Tissu présent partout où il faut de la résistance : peau, vaisseaux sanguins, cœur, intestin, nerf, muscles, etc. CELLULES: Les fibroblastes fabriquent les fibres du tissu. FIBRES: • Collagène : donnent au tissu sa résistance, et forment de la gélatine à la chaleur; • Fibres élastiques : assurent l’élasticité du tissu • Fibres réticulaires Les globules blancs repèrent et détruisent les micro-organismes qui pourraient envahir le tissu. Les cellules adipeuses accumulent les lipides. Globule blanc Fibroblaste Fibre élastique Fibre réticulaire Globule blanc Fibre de collagène Globule blanc Substance fondamentale Cellule adipeuse Capillaire sanguin
Tissu conjonctif lâche Fibres élastiques (fines) Noyau des fibroblastes Fibres de collagène Globules blancs Les fibres réticulaires sont trop fines pour être vues au microscope optique.
Conjonctif adipeux = tissu conjonctif lâche envahi par des cellules adipeuses (adipocytes) • Réserve d’énergie • Protection mécanique : les reins, sont entourés d'une gaine de gras qui les protège. • Isolant thermique : chez les oiseaux ou mammifères marins. Cellule adipeuse (adipocyte) Vésicule remplie de lipides Noyau et organites cellulaires
Conjonctif fibreux = assemblage très dense de fibres parallèles de collagène • Les tendons relient un muscle à un os. • Les ligaments, un os à un os.
Cartilage ou tissu cartilagineux = fibres de collagène enrobées d ’une substance fondamentale solide: chondroïtine-phosphate Fibres et substance fondamentale sécrétées par des chondroblastes (Chondroblastes matures = chondrocytes) Le cartilage recouvre les articulation et forme certaines parties souples du corps comme l'extrémité du nez ou le larynx (la "pomme d'Adam"). L'arthrite est causée par la destruction du cartilage recouvrant les articulations
Tissu osseux Formé de cellules, les ostéoblastes qui sécrètent: Fibres de collagène (flexibilité) ; minéraux, phosphate et calcium (rigidité) Contient de nombreux vaisseaux sanguins Ostéoblastes matures = ostéocytes Un os long, comme ceux des jambes ou des bras, est formé de matière osseuse disposée en lamelles périphériques et en colonnes faites de lamelles concentriques). Remarquez les vaisseaux sanguins qui irriguent le tissu. On retrouve une veine et un artère au centre de chacune des colonnes osseuses. Les ostéocytes sont reliés entre eux par de petits canaux, les canalicules.
Tissu sanguin Le sang est un tissu liquide qui peut devenir solide (coagulation). Le plasma sanguin est un liquide dans lequel baignent les éléments figurés du sang. Les éléments figurés du sang : - globules blancs : peu nombreux et plus grands -globules rouges : plus nombreux et plus petits, et ne contiennent pas de noyau - plaquettes sanguines : jouent un rôle important dans la coagulation sanguine
Tissus musculaires = Cellules : allongées, excitables, contractiles. Suite à une excitation, les cellules musculaires peuvent se raccourcir. Elles se contractent. Trois types de muscles: Muscle squelettique Muscle lisse Muscle cardiaque
Muscle squelettique ou muscle strié • Cellules cylindriques très longues: on les appelle "fibres musculaires" contenant des faisceaux de myofibrilles et plusieurs noyaux. • Les cellules musculaires ne peuvent pas se multiplier. Elles sont responsables des contractions volontaires • L'exercice physique n’augmente pas le nombre de cellules dans le muscle, mais seulement leur volume (le nombre de myofilaments). Les myofibrilles sont formées de faisceaux de myofilaments (protéines responsables de la contraction). Il y a deux sortes de myofilaments: l'actine et la myosine RELAXATION CONTRACTION
Muscle lisse • Forme les muscles involontaires : tube digestif, utérus, entoure les vaisseaux sanguins, etc. • Cellules courtes non striées • Un seul noyau par cellule • Contractions lentes, mais soutenues
Muscle cardiaque • = principales cellules du cœur • Cellules courtes, mais striées • Cellules ramifiées (forment un « filet » ) • Cellules reliées les unes aux autres par des disques intercalaires • Contractions rythmiques involontaires
Tissu nerveux • Formé de cellules nerveuses = neurones • Chaque neurone est formé: - d ’un corps cellulaire - de prolongements fins = axone et dendrites Les neurones communiquent les uns avec les autres par des connexions entre leurs prolongements (synapse). Ils forment dans le système nerveux de complexes réseaux électriques. • Ne peuvent pas se reproduire après la naissance • Cellules excitables (peuvent réagir à un stimulus) Prolongements Corps cellulaire